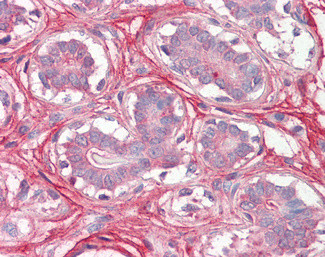
Decorin Antibody in Immunohistochemistry (Paraffin) (IHC (P))

Search
Invitrogen
Decorin Polyclonal Antibody
{{$productOrderCtrl.translations['antibody.pdp.commerceCard.promotion.promotions']}}
{{$productOrderCtrl.translations['antibody.pdp.commerceCard.promotion.viewpromo']}}
{{$productOrderCtrl.translations['antibody.pdp.commerceCard.promotion.promocode']}}: {{promo.promoCode}} {{promo.promoTitle}} {{promo.promoDescription}}. {{$productOrderCtrl.translations['antibody.pdp.commerceCard.promotion.learnmore']}}



Please note: We are reviewing Western blot images included in the antibody testing data in our catalog, including those provided by third parties. Unless expressly labeled or annotated as “raw-unedited”, Western blot images included in the antibody testing data in our catalog may have been edited, optimized or otherwise adjusted for presentation.
产品信息
PA5-19151
种属反应
宿主/亚型
分类
类型
抗原
偶联物
形式
浓度
规格
纯化类型
保存液
内含物
保存条件
运输条件
RRID
产品详细信息
This antibody is predicted to react with bovine, porcine and Cavia rodent based on sequence homology.
This antibody is tested in Peptide ELISA: antibody detection limit dilution 8,000.
靶标信息
Decorin is a member of the small, leucine-rich proteoglycan (SLRP) family along with biglycan. Found in the interterritorial region of cartilage, decorin interacts with collagen and other matrix proteins to regulate the cartilaginous matrix. It has been shown to interact with fibronectin, thrombospondin, C1q, epidermal growth factor receptor (EGFR), and TGF-b. It is believed that decorin also plays a role in the cell cycle of chondrocytes. The decorin neoepitope fragment has a sequence of PKTLQE, and is generated by MMP-3 or ADAMTS-4 cleavage at Glu154-Leu155 of decorin core protein.
仅用于科研。不用于诊断过程。未经明确授权不得转售。
生物信息学
蛋白别名: Dermatan sulphate proteoglycans II (DSPG2); Small leucine rich protein 1B